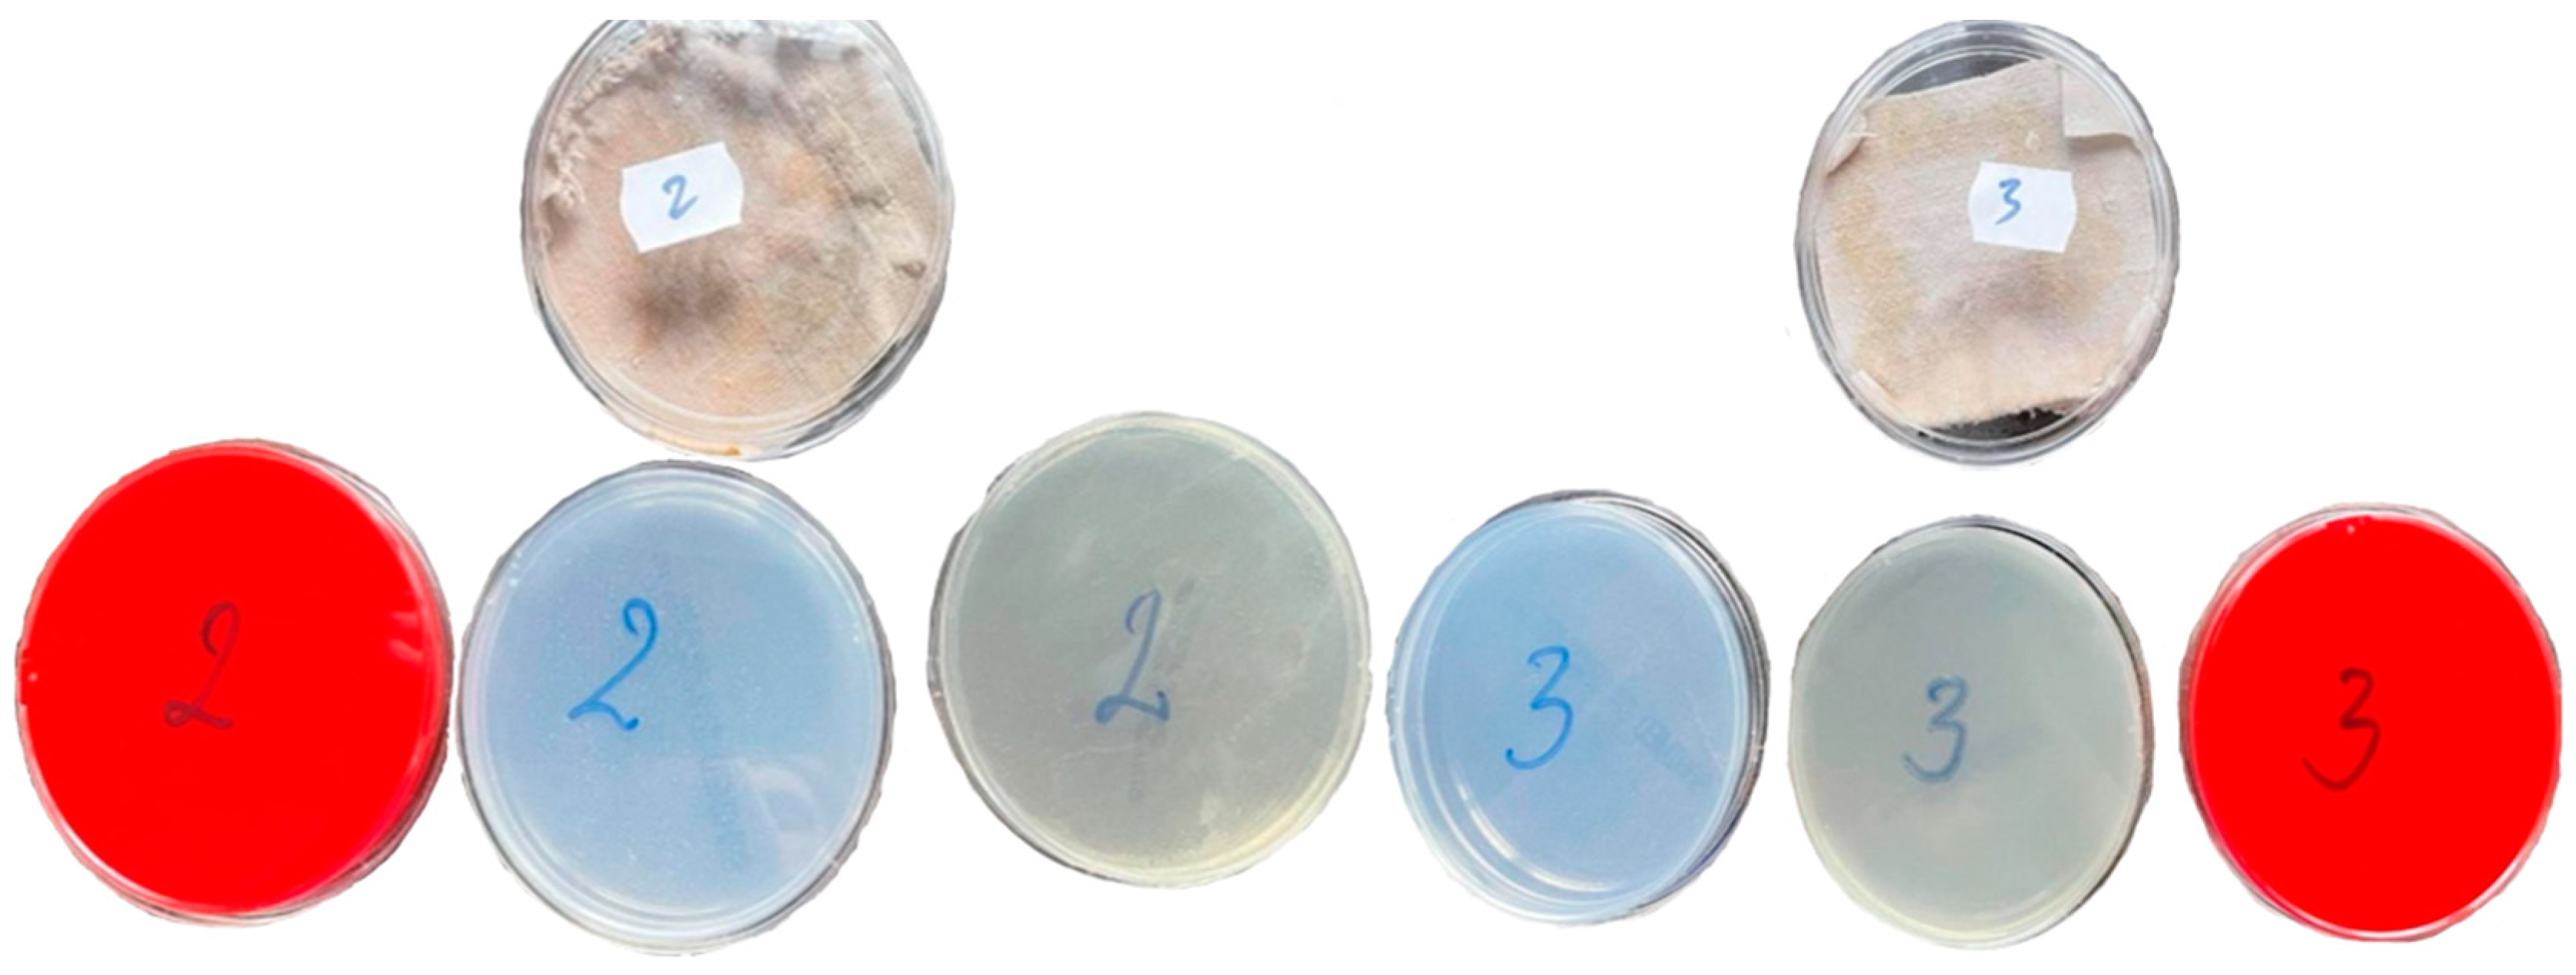
Coatings 12 01688 g005 Coatings 12 01688 g005

Antibacterial Effect of Eco-Friendly Silver Nanoparticles and Traditional Techniques on Aged Heritage Textile, Investigated by Dark-Field Microscopy
Abstract
1. Introduction
2. Literature Review
3. Materials and Methods
3.1. Preliminary Microbiological Analyses
3.2. Antibacterial Interventions
Washing with Lye
3.3. Application of Silver Nanoparticles (AgNPs)
3.4. Samples Analysis
4. Results and Discussions
4.1. Preliminary Microbiological Analyses
4.2. Antibacterial Interventions
5. Conclusions
6. Perspective
- -
- In the processes of obtaining silver nanoparticles, the use of certain plant extracts obtained from plants specific to areas from which the cult objects analyzed in this study come as reducer and stabilizing agents to stabilize the silver nanoparticles and follow the dynamics of the rate of increase of silver nanoparticles depending on the operating conditions.
- -
- Expanding the research using gold nanoparticles obtained using the vegetable extracts mentioned in the previous paragraph and comparing their efficiency to those of nanosilver obtained under the same working conditions.
- -
- Synthesis of nanomaterials with controlled properties, using environmentally friendly reagents.
Author Contributions
Funding
Institutional Review Board Statement
Informed Consent Statement
Data Availability Statement
Acknowledgments
Conflicts of Interest
References
- Pasquariello, G.; Crupi, G.; Strippoli, S.; Maggi, O.; Colaizzi, P.; Balocco, C.; Albertini, R.; Pasquarella, C. Microbial environmental monitoring in museums: Preventive conservation of graphic collections. Conserv. Sci. Cult. Herit. 2016, 14, 275–289. [Google Scholar]
- Franco-Castillo, I.; Hierro, L.; de la Fuente, J.M.; Seral-Ascaso, A.; Mitchell, S.G. Perspectives for Antimicrobial Nanomaterials in Cultural Heritage Conservation. Chem 2021, 7, 629–669. [Google Scholar] [CrossRef]
- Ilieș, D.C.; Hodor, N.; Indrie, L.; Dejeu, P.; Ilieș, A.; Albu, A.; Caciora, T.; Ilieș, M.; Barbu-Tudoran, L.; Grama, V. Investigations of the Surface of Heritage Objects and Green Bioremediation: Case Study of Artefacts from Maramureş, Romania. Appl. Sci. 2021, 11, 6643. [Google Scholar] [CrossRef]
- Ilieș, D.C.; Marcu, F.; Caciora, T.; Indrie, L.; Ilieș, A.; Albu, A.; Costea, M.; Burtă, L.; Baias, Ș.; Ilieș, M.; et al. Investigations of Museum Indoor Microclimate and Air Quality. Case Study from Romania. Atmosphere 2021, 12, 286. [Google Scholar] [CrossRef]
- Ilies, D.C.; Zlatev, Z.; Ilies, A.; Zharas, B.; Pantea, E.; Hodor, N.; Indrie, L.; Turza, A.; Taghiyari, H.R.; Caciora, T.; et al. Interdisciplinary Research to Advance Digital Imagery and Natural Compounds for Eco-Cleaning and for Preserving Textile Cultural Heritage. Sensors 2022, 22, 4442. [Google Scholar] [CrossRef]
- Wendt, J.A.; Indrie, L.; Dejeu, P.; Albu, A.; Ilieș, D.C.; Costea, M.; Caciora, T.; Ilieș, G.; Hodor, N.; Josan, I.; et al. Natural Sources in Preventive Conservation of Naturally Aged Textiles. Fibres Text. East. Eur. 2021, 29, 80–85. [Google Scholar] [CrossRef]
- Bou-Belda, E.; Indrie, L.; Ilies, D.C.; Hodor, N.; Berdenov, Z.; Herman, G.V.; Caciora, T. Chitosan—A non-invasive approach for the preservation of historical textiles. Ind. Text. 2020, 71, 576–579. [Google Scholar] [CrossRef]
- Marcu, F.; Ilieș, D.C.; Wendt, I.A.; Indrie, L.; Ilieș, A.; Burta, L.; Caciora, T.; Herman, G.V.; Baias, S.; Albu, A. Investigations Regarding the Biodegradation of the Cultural Heritage. Case Study of Traditional Embroidered Peasant Shirt (Maramures, Romania). Rom. Biotechnol. Lett. 2020, 25, 1362–1368. [Google Scholar] [CrossRef]
- Demenchuk, E.; Ilies, D.C.; Wendt, J.A.; Koroleva, Y.; Ilies, A.; Goikhman, A.; Maznitsyna, E.; Caciora, T.; Herman, G.; Bilcec, M. Spectroscopy study of heritage objects for the digitization of cultural heritage. J. Environ. Eng. Landsc. Manag. 2020, 19, 1057–1066. [Google Scholar]
- Lazic, V.; Vadrucci, M.; Fantoni, R.; Chiari, M.; Mazzinghi, A.; Gorghinian, A. Applications of Laser-Induced Breakdown Spectroscopy for Cultural Heritage: A Comparison with X-ray Fluorescence and Particle Induced X-ray Emission Techniques. Spectrochim. Acta Part B At. Spectrosc. 2018, 149, 1–14. [Google Scholar] [CrossRef]
- Xu, K.; Sun, W.; Shao, Y.; Wei, F.; Zhang, X.; Wang, W.; Li, P. Recent Development of PeakForce Tapping Mode Atomic Force Microscopy and Its Applications on Nanoscience. Nanotechnol. Rev. 2018, 7, 605–621. [Google Scholar] [CrossRef]
- Caciora, T.; Herman, G.V.; Baias, S. Computer analysis of a heritage item—The traditional sheepskin waistcoat in Beius area. Rev. Etnogr. Folc. J. Ethnogr. Folk. 2021, 1–2, 195–209. [Google Scholar]
- Albu, A.V.; Caciora, T.; Berdenov, Z.; Ilies, D.C.; Sturzu, B.; Sopota, D.; Herman, G.V.; Ilies, A.; Kecse, G.; Ghergheles, C.G. Digitalization of garment in the context of circular economy. Ind. Text. 2021, 74, 102–107. [Google Scholar] [CrossRef]
- Guiamet, P.S.; Gómez de Saravia, S.G.; Arenas, P.; Pérez, M.L.; De la Paz, J.; Borrego, S.F. Natural products isolated from plants used in biodeterioration control. Pharmacologyonline 2006, 3, 537–544. [Google Scholar]
- Barresi, G.; Carlo, E.; Trapani, M.R.; Parisi, M.G.; Chillè, C.; Mulè, M.F.; Cammarata, M.; Palla, F. Marine organisms as source of bioactive molecules applied in restoration projects. Herit. Sci. 2015, 3, 17–20. [Google Scholar] [CrossRef]
- Borrego, S.; Valdés, O.; Vivar, I.; Lavin, P.; Guiamet, P.; Battistoni, P.; Gómez de Saravia, S.; Borges, P. Essential oils of plants as biocides against microorganisms isolated from Cuban and Argentine Documentary heritage. ISRN Microbiol. 2012, 826786. [Google Scholar] [CrossRef]
- Zhang, F.; Wu, X.; Chen, Y.; Lin, H. Application of Silver Nanoparticles to Cotton Fabric as an Antibacterial Textile Finish. Fibers Polym. 2009, 10, 496–501. [Google Scholar] [CrossRef]
- Pietrzak, K.; Gutarowska, B.; Machnowski, W.; Mikołajczyk, U. Antimicrobial Properties of Silver Nanoparticles Misting on Cotton Fabrics. Text. Res. J. 2016, 86, 812–822. [Google Scholar] [CrossRef]
- Burniston, N.; Bygott, C.; Stratton, J. Nano Technology Meets Titanium Dioxide. Surface Coat. Int. Part A 2004, 87, 179–814. [Google Scholar]
- Kanti Das, T.; Ganguly, S.; Remanan, S.; Das, N.C. Temperature-dependent Study of Catalytic Ag Nanoparticles Entrapped Resin Nanocomposite towards Reduction of 4-nitrophenol. ChemistrySelect 2019, 4, 3665–3671. [Google Scholar] [CrossRef]
- Das, T.K.; Remanan, S.; Ghosh, S.; Das, N.C. An Environment Friendly Free-Standing Cellulose Membrane Derived for Catalytic Reduction of 4-Nitrophenol: A Sustainable Approach. J. Environ. Chem. Eng. 2021, 9, 104596. [Google Scholar] [CrossRef]
- Lei, Q.; Juan, P.H. Application of nanotechnology for high performance textile. J. Text. Appar. Technol. Manag. 2003, 4, 1–8. [Google Scholar]
- Diaz-Visurraga, J.; Gutierrez, C.; von Plessing, C.; Garcia, A. Metalnanostructures as antibacterial agents. In Science against Microbial Pathogens: Communicating Current Research and Technological Advances; Mendez-Vilas, A., Ed.; Formatex: Badajoz, Spain, 2011; pp. 210–218. [Google Scholar]
- Bashiri Rezaie, A.; Montazer, M.; Mahmoudi Rad, M. Scalable, Eco-Friendly and Simple Strategy for Nano-Functionalization of Textiles Using Immobilized Copper-Based Nanoparticles. Clean Technol. Environ. Policy 2018, 20, 2119–2133. [Google Scholar] [CrossRef]
- Agarwal, H.; Nakara, A.; Menon, S.; Shanmugam, V. Eco-Friendly Synthesis of Zinc Oxide Nanoparticles Using Cinnamomum Tamala Leaf Extract and Its Promising Effect towards the Antibacterial Activity. J. Drug Deliv. Sci. Technol. 2019, 53, 101212. [Google Scholar] [CrossRef]
- Fouda, A.; Abdel-Maksoud, G.; Abdel-Rahman, M.A.; Salem, S.S.; Hassan, S.E.-D.; El-Sadany, M.A.-H. Eco-Friendly Approach Utilizing Green Synthesized Nanoparticles for Paper Conservation against Microbes Involved in Biodeterioration of Archaeological Manuscript. Int. Biodeterior. Biodegrad. 2019, 142, 160–169. [Google Scholar] [CrossRef]
- Kagithoju, S.; Godishala, V.; Nanna, R.S. Eco-Friendly and Green Synthesis of Silver Nanoparticles Using Leaf Extract of Strychnos Potatorum Linn.F. and Their Bactericidal Activities. 3 Biotech 2015, 5, 709–714. [Google Scholar] [CrossRef]
- Hamad, A.; Khashan, K.S.; Hadi, A. Silver Nanoparticles and Silver Ions as Potential Antibacterial Agents. J. Inorg. Organomet. Polym. Mater. 2020, 30, 4811–4828. [Google Scholar] [CrossRef]
- Stuart, B.H. Analytical Techniques in Materials Conservation; John Wiley & Sons: Hoboken, NJ, USA, 2007. [Google Scholar] [CrossRef]
- Piñar, G.; Sterflinger, K. Natural Sciences at the Service of Art and Cultural Heritage: An Interdisciplinary Area in Development and Important Challenges. Microb. Biotechnol. 2021, 14, 806–809. [Google Scholar] [CrossRef]
- Chen, C.-C.; Wactlar, H.D.; Wang, J.Z.; Kiernan, K. Digital Imagery for Significant Cultural and Historical Materials. Int. J. Digit. Libr. 2005, 5, 275–286. [Google Scholar] [CrossRef]
- Stork, D. Computer Image Analysis of Paintings and Drawings: An Introduction to the Literature. In Proceedings of the Image Processing for Artist Identification Workshop, Amsterdam, The Netherlands, 20 June 2008. [Google Scholar]
- Ivanova, K.; Dobreva, M.; Stanchev, P.; Totkov, G. Access to Digital Cultural Heritage: Innovative Applications of Automated Metadata Generation; Plovdiv University Publishing House “Paisii Hilendarski”: Plovdiv, Bulgaria, 2012; p. 249. [Google Scholar]
- Bicchieri, M.; Biocca, P.; Colaizzi, P.; Pinzari, F. Microscopic Observations of Paper and Parchment: The Archaeology of Small Objects. Herit. Sci. 2019, 7, 47. [Google Scholar] [CrossRef]
- Fistos, T.; Fierascu, I.; Fierascu, R.C. Recent Developments in the Application of Inorganic Nanomaterials and Nanosystems for the Protection of Cultural Heritage Organic Artifacts. Nanomaterials 2022, 12, 207. [Google Scholar] [CrossRef]
- Logofătu, P.C.; Vasile, N.T. Image resampling by interpolation guided by sensor geometry. Rom. Rep. Phys. 2021, 73, 402. [Google Scholar]
- Karimi, A.; Taghiyari, H.R.; Fattahi, A.; Karimi, S.; Ebrahimi, G.; Tarmian, A. Effects of Wollastonite Nanofibers on Biological Durability of Poplar Wood (Populus Nigra) against Trametes Versicolor. BioResources 2013, 8, 4134–4141. [Google Scholar] [CrossRef]
- Lykidis, C.; Mantanis, G.; Adamopoulos, S.; Kalafata, K.; Arabatzis, I. Effects of Nano-Sized Zinc Oxide and Zinc Borate Impregnation on Brown Rot Resistance of Black Pine (Pinus nigra L.) Wood. Wood Mat. Sci. Eng. 2013, 8, 242–244. [Google Scholar] [CrossRef]
- Taghiyari, H.R.; Norton, J.; Tajvidi, M. Effects of Nano-Materials on Different Properties of Wood-Composite Materials. In Bio-Based Wood Adhesives: Preparation, Characterization, and Testing; CRC Press/Taylor & Francis Group: Boca Raton, FL, USA, 2017; pp. 310–339. [Google Scholar]
- Taghiyari, H.R.; Bari, E.; Sistani, A.; Najafian, M.; Ghanbary, M.A.T.; Ohno, K.M. Biological Resistance of Nanoclay-Treated Plastic Composites with Different Bamboo Contents to Three Types of Fungi. J. Thermoplast. Compos. Mater. 2020, 33, 1048–1060. [Google Scholar] [CrossRef]
- Taghiyari, H.R.; Moradi-Malek, B.; Ghorbani Kookandeh, M.; Farajpour Bibalan, O. Effects of Silver and Copper Nanoparticles in Particleboard to Control Trametes Versicolor Fungus. Int. Biodeterior. Biodegrad. 2014, 94, 69–72. [Google Scholar] [CrossRef]
- Taghiyari, H.R.; Kalantari, A.; Ghorbani, M.; Bavaneghi, F.; Akhtari, M. Effects of Fungal Exposure on Air and Liquid Permeability of Nanosilver- and Nanozincoxide-Impregnated Paulownia Wood. Int. Biodeterior. Biodegrad. 2015, 105, 51–57. [Google Scholar] [CrossRef]
- Taghiyari, H.R.; Bari, E.; Schmidt, O.; Ghanbary, M.A.T.; Karimi, A.; Tahir, P.M.D. Effects of Nanowollastonite on Biological Resistance of Particleboard Made from Wood Chips and Chicken Feather against Antrodia Vaillantii. Int. Biodeterior. Biodegrad. 2014, 90, 93–98. [Google Scholar] [CrossRef]
- Taghiyari, H.R.; Bari, E.; Schmidt, O. Effects of Nanowollastonite on Biological Resistance of Medium-Density Fiberboard against Antrodia Vaillantii. Eur. J. Wood Wood Product. 2014, 72, 399–406. [Google Scholar] [CrossRef]
- Taghiyari, H.R.; Majidinajafabadi, R.; Vahidzadeh, R. Wollastonite to Hinder Growth of Aspergillus Niger Fungus on Cotton Textile. An. Acad. Bras. Cienc. 2018, 90, 2797–2804. [Google Scholar] [CrossRef]
- Taghiyari, H.R.; Kalantari, A.; Kalantari, A.; Avramidis, S. Effect of Wollastonite Nanofibers and Exposure to Aspergillus Niger Fungus on Air Flow Rate in Paper. Measurement 2019, 136, 307–313. [Google Scholar] [CrossRef]
- Yang, H.; Zhu, S.; Pan, N. Studying the Mechanisms of Titanium Dioxide as Ultraviolet-Blocking Additive for Films and Fabrics by an Improved Scheme. J. Appl. Polym. Sci. 2004, 92, 3201–3210. [Google Scholar] [CrossRef]
- Rai, M.; Yadav, A.; Gade, A. Silver Nanoparticles as a New Generation of Antimicrobials. Biotechnol. Adv. 2009, 27, 76–83. [Google Scholar] [CrossRef]
- Liu, H.; Lee, Y.-Y.; Norsten, T.B.; Chong, K. In Situ Formation of Anti-Bacterial Silver Nanoparticles on Cotton Textiles. J. Ind. Text. 2014, 44, 198–210. [Google Scholar] [CrossRef]
- Simončič, B.; Klemenčič, D. Preparation and Performance of Silver as an Antimicrobial Agent for Textiles: A Review. Text. Res. J. 2016, 86, 210–223. [Google Scholar] [CrossRef]
- Gokarneshan, N.; Velumani, K. Application of Nano Silver Particles on Textile Materials for Improvement of Antibacterial Finishes. Glob. J. Nanomed. 2017, 2, 42–45. [Google Scholar]
- Radetić, M. Functionalization of Textile Materials with Silver Nanoparticles. J. Mater. Sci. 2013, 48, 95–107. [Google Scholar] [CrossRef]
- Perkas, N.; Perelshtein, I.; Gedanken, A. Coating Textiles with Antibacterial Nanoparticles Using the Sonochemical Technique, Journal of Machine Construction and Maintenance. J. Mach. Constr. Maint. 2018, 4, 15–26. [Google Scholar]
- Khe, Y.; Sv, M.; Aa, S.; Jz, J.; Fm, T.; Ssh, R.; Renat, L. Antibacterial Effect of Cotton Fabric Treated with Silver Nanoparticles of Different Sizes and Shapes. Int. J. Nanomater. Nanotechnol. Nanomed. 2019, 5, 016–023. [Google Scholar] [CrossRef]
- Sivasanmugam, S.Y. Silver Nanoparticle Impregnated Biomedical Fiber. Int. J. RF Technol. Res. Appl. 2015, 3, 194–197. [Google Scholar]
- Wu, Y.; Yang, Y.; Zhang, Z.; Wang, Z.; Zhao, Y.; Sun, L. Fabrication of Cotton Fabrics with Durable Antibacterial Activities Finishing by Ag Nanoparticles. Text. Res. J. 2019, 89, 867–880. [Google Scholar] [CrossRef]
- Monteiro, D.R.; Gorup, L.F.; Silva, S.; Negri, M.; de Camargo, E.R.; Oliveira, R.; Barbosa, D.B.; Henriques, M. Silver Colloidal Nanoparticles: Antifungal Effect against Adhered Cells and Biofilms of Candida Albicans and Candida Glabrata. Biofouling 2011, 27, 711–719. [Google Scholar] [CrossRef] [PubMed]
- Cameron, P.; Gaiser, B.K.; Bhandari, B.; Bartley, P.M.; Katzer, F.; Bridle, H. Silver Nanoparticles Decrease the Viability of Cryptosporidium Parvum Oocysts. Appl. Environ. Microbiol. 2016, 82, 431–437. [Google Scholar] [CrossRef] [PubMed]
- Duran, N.; Marcato, P.D.; De Souza, G.I.H.; Alves, O.L.; Esposito, E. Antibacterial Effect of Silver Nanoparticles Produced by Fungal Process on Textile Fabrics and Their Effluent Treatment. J. Biomed. Nanotechnol. 2007, 3, 203–208. [Google Scholar] [CrossRef]
- Rojas-Lema, S.P.; Galeas-Hurtado, S.G.; Guerrero-Barragán, V.H. Improvement of silver nanoparticle impregnation on cotton fabrics using a binder. Rev. Fac. Ing. 2017, 26, 109–119. [Google Scholar] [CrossRef]
- Montes-Hernandez, G.; Di Girolamo, M.; Sarret, G.; Bureau, S.; Fernandez-Martinez, A.; Lelong, C.; Eymard Vernain, E. In Situ Formation of Silver Nanoparticles (Ag-NPs) onto Textile Fibers. ACS Omega 2021, 6, 1316–1327. [Google Scholar] [CrossRef]
- Kim, S.-H.; Lee, H.-S.; Ryu, D.-S.; Choi, S.-J.; Lee, D.-S. Antibacterial Activity of Silver-Nanoparticles Against Staphylococcus Aureus and Escherichia Coli. Microbiol. Biotechnol. Lett. 2011, 39, 77–85. [Google Scholar]
- Balakumaran, R.R.; Jagadeeswari, S.; Kalaichelvan, P.T. In Vitro Biological Properties and Characterization of Nanosilver Coated Cotton Fabrics—An Application for Antimicrobial Textile Finishing. Int. Biodeterior. Biodegrad. 2016, 107, 48–55. [Google Scholar] [CrossRef]
- Vishnupriya, S.; Chaudhari, K.; Jagannathan, R.; Pradeep, T. Single-Cell Investigations of Silver Nanoparticle-Bacteria Interactions. Part. Part. Syst. Charact. 2013, 30, 1056–1062. [Google Scholar] [CrossRef]
- Roth, G.A.; Sosa Peña, M.d.P.; Neu-Baker, N.M.; Tahiliani, S.; Brenner, S.A. Identification of Metal Oxide Nanoparticles in Histological Samples by Enhanced Darkfield Microscopy and Hyperspectral Mapping. J. Vis. Exp. 2015, 106, e53317. [Google Scholar] [CrossRef]
- Neu-Baker, N.M.; Eastlake, A.C.; Brenner, S.A. Sample Preparation Method for Visualization of Nanoparticulate Captured on Mixed Cellulose Ester Filter Media by Enhanced Darkfield Microscopy and Hyperspectral Imaging. Microsc. Res. Techn. 2019, 82, 878–883. [Google Scholar] [CrossRef]
- Shi, R.; Chen, X.; Huo, J.; Guo, S.; Smith, Z.J.; Chu, K. Epi-Illumination Dark-Field Microscopy Enables Direct Visualization of Unlabeled Small Organisms with High Spatial and Temporal Resolution. J. Biophotonics 2022, 15, e202100185. [Google Scholar] [CrossRef] [PubMed]
- Badireddy, A.R.; Wiesner, M.R.; Liu, J. Detection, Characterization, and Abundance of Engineered Nanoparticles in Complex Waters by Hyperspectral Imagery with Enhanced Darkfield Microscopy. Environ. Sci. Technol. 2012, 46, 10081–10088. [Google Scholar] [CrossRef] [PubMed]
- Hebeish, A.; El-Naggar, M.E.; Fouda, M.M.G.; Ramadan, M.A.; Al-Deyab, S.S.; El-Rafie, M.H. Highly Effective Antibacterial Textiles Containing Green Synthesized Silver Nanoparticles. Carbohydr. Polym. 2011, 86, 936–940. [Google Scholar] [CrossRef]
- Saad, E.R.; Hafez, N.M. Effect of Coating with Silver Nanoparticles (AgNPs) on Cotton Fabric Functional Properties. Int. Des. J. 2014, 4, 33–39. [Google Scholar]
- Memon, H.; Wang, H.; Yasin, S.; Halepoto, A. Influence of Incorporating Silver Nanoparticles in Protease Treatment on Fiber Friction, Antistatic, and Antibacterial Properties of Wool Fibers. J. Chem. Chem. Eng. 2018, 4845687. [Google Scholar] [CrossRef]
- Shahverdi, A.R.; Fakhimi, A.; Shahverdi, H.R.; Minaian, S. Synthesis and Effect of Silver Nanoparticles on the Antibacterial Activity of Different Antibiotics against Staphylococcus Aureus and Escherichia Coli. Nanomedicine 2007, 3, 168–171. [Google Scholar] [CrossRef] [PubMed]
- Ribeiro, A.I.; Shvalya, V.; Cvelbar, U.; Silva, R.; Marques-Oliveira, R.; Remião, F.; Felgueiras, H.P.; Padrão, J.; Zille, A. Stabilization of Silver Nanoparticles on Polyester Fabric Using Organo-Matrices for Controlled Antimicrobial Performance. Polymers 2022, 14, 1138. [Google Scholar] [CrossRef]
- Selvakumar, R.; Suriyaraj, S.P.; Jayavignesh, V.; Swaminathan, K. Silver nanoparticle impregnated bio-based activated carbon with enhanced antimicrobial activity. Int. J. Nanosci. 2013, 12, 1350024. [Google Scholar] [CrossRef]

| Article | Methodology | |||||||||||||||
|---|---|---|---|---|---|---|---|---|---|---|---|---|---|---|---|---|
| Dark Field Microscopy | Year | SEM | SM | EDFM | EDS | DLS | ESI | NIOSH Method 7400/CDC-NIOSH | NPs | TOF-SIMS | TEM | AFM | UVS | X-ray | FTIR | HI |
| Roth et al. [65] | 2015 | ✓ | ✓ | ✓ | ||||||||||||
| Neu-Baker et al. [66] | 2019 | ✓ | ✓ | ✓ | ||||||||||||
| Shi et al. [67] | 2022 | ✓ | ✓ | ✓ | ||||||||||||
| Badireddy et al. [68] | 2012 | ✓ | ✓ | ✓ | ||||||||||||
| Vishnupriya et al. [64] | 2013 | ✓ | ✓ | |||||||||||||
| AgNPs Cotton fibers | ||||||||||||||||
| Duran et al. [59] | 2007 | ✓ | ✓ | ✓ | ✓ | ✓ | ✓ | |||||||||
| Liu et al. [49] | 2014 | ✓ | ✓ | ✓ | ✓ | |||||||||||
| Hebeish et al. [69] | 2011 | ✓ | ✓ | |||||||||||||
| Khe et al. [54] | 2019 | ✓ | ✓ | ✓ | ✓ | |||||||||||
| Rojas-Lema et al. [60] | 2017 | ✓ | ✓ | ✓ | ||||||||||||
| Perkas et al. [53] | 2018 | ✓ | ✓ | ✓ | ✓ | |||||||||||
| Balakumaran et al. [63] | 2016 | ✓ | ✓ | ✓ | ✓ | ✓ | ||||||||||
| Saad and Hafez [70] | 2014 | ✓ | ✓ | |||||||||||||
| Wool fibers | ||||||||||||||||
| Memon et al. [71] | 2018 | ✓ | ✓ | ✓ | ||||||||||||
| Gokarneshan and Velumani [51] | 2017 | ✓ | ✓ | ✓ | ||||||||||||
| Shahverdi et al. [72] | 2007 | ✓ | ✓ | ✓ | ✓ | |||||||||||
| Montes-Hernandez et al. [61] | 2021 | ✓ | ✓ | ✓ | ||||||||||||
| Polyester fibers | ||||||||||||||||
| Ribeiro et al. [73] | 2022 | ✓ | ✓ | ✓ | ✓ | |||||||||||
| Medical fibres | ||||||||||||||||
| Selvakumar et al. [74] | 2013 | ✓ | ✓ | ✓ | ||||||||||||
Publisher’s Note: MDPI stays neutral with regard to jurisdictional claims in published maps and institutional affiliations. |
© 2022 by the authors. Licensee MDPI, Basel, Switzerland. This article is an open access article distributed under the terms and conditions of the Creative Commons Attribution (CC BY) license (https://creativecommons.org/licenses/by/4.0/).
Share and Cite
Ilieș, A.; Hodor, N.; Pantea, E.; Ilieș, D.C.; Indrie, L.; Zdrîncă, M.; Iancu, S.; Caciora, T.; Chiriac, A.; Ghergheles, C.; et al. Antibacterial Effect of Eco-Friendly Silver Nanoparticles and Traditional Techniques on Aged Heritage Textile, Investigated by Dark-Field Microscopy. Coatings 2022, 12, 1688. https://doi.org/10.3390/coatings12111688
Ilieș A, Hodor N, Pantea E, Ilieș DC, Indrie L, Zdrîncă M, Iancu S, Caciora T, Chiriac A, Ghergheles C, et al. Antibacterial Effect of Eco-Friendly Silver Nanoparticles and Traditional Techniques on Aged Heritage Textile, Investigated by Dark-Field Microscopy. Coatings. 2022; 12(11):1688. https://doi.org/10.3390/coatings12111688
Chicago/Turabian StyleIlieș, Alexandru, Nicolaie Hodor, Emilia Pantea, Dorina Camelia Ilieș, Liliana Indrie, Mihaela Zdrîncă, Stefania Iancu, Tudor Caciora, Alexandra Chiriac, Carmen Ghergheles, and et al. 2022. "Antibacterial Effect of Eco-Friendly Silver Nanoparticles and Traditional Techniques on Aged Heritage Textile, Investigated by Dark-Field Microscopy" Coatings 12, no. 11: 1688. https://doi.org/10.3390/coatings12111688
APA StyleIlieș, A., Hodor, N., Pantea, E., Ilieș, D. C., Indrie, L., Zdrîncă, M., Iancu, S., Caciora, T., Chiriac, A., Ghergheles, C., Taghiyari, H. R., Costea, M., & Baias, Ș. (2022). Antibacterial Effect of Eco-Friendly Silver Nanoparticles and Traditional Techniques on Aged Heritage Textile, Investigated by Dark-Field Microscopy. Coatings, 12(11), 1688. https://doi.org/10.3390/coatings12111688

